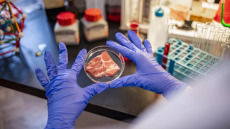
Εργαστηριακό κρέας: Τα πλεονεκτήματα και τα διλήμματα της κατανάλωσής του – Ένας καθηγητής εξηγεί

Στα έντομα και (μελλοντικά) το τεχνητό κρέας βασίζεται το πλάνο της ΕΕ για ένα βιώσιμο διατροφικό σύστημα - Πόσο έτοιμοι είναι οι Έλληνες να φάνε γρύλους και σκουλήκια; Τι ελπίδες έχει το τεχνητό κρέας; Έρευνες απαντούν
Το «εργαστηριακό» κρέας έχει γίνει σημαντικό θέμα συζήτησης τόσο στους τομείς της επιστήμης των τροφίμων όσο και της ηθικής. Παράγεται με την καλλιέργεια ζωικών κυττάρων σε ελεγχόμενο περιβάλλον, παρακάμπτοντας την ανάγκη εκτροφής και σφαγής ζώων. Αυτή η καινοτομία ωστόσο προσφέρει πολλά οφέλη, αλλά εγείρει και ηθικά ερωτήματα